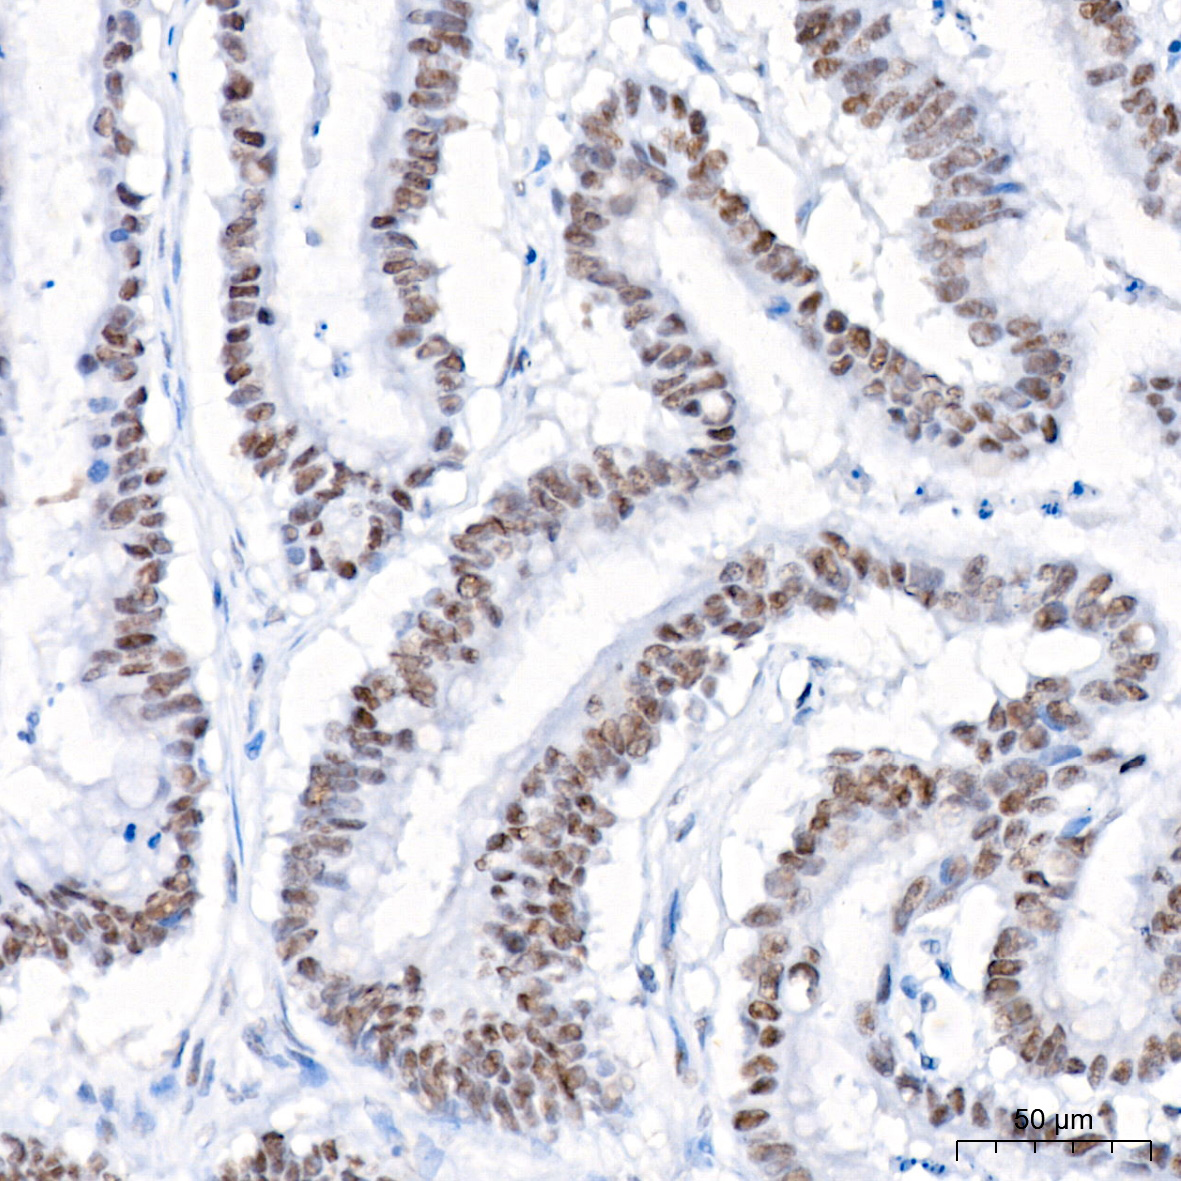

CATALOG NUMBER: 83-675
FOR RESEARCH USE ONLY
For additional information, visit ProSci’s Terms & Conditions Page.
$65 Standard Overnight flat rate for as many products shipped within the United States.
$35 Dry Ice Shipment fee may be required on some items.
Note: Online orders only accepted for shipment within the USA. Click here for the list of international distributors.
Bulk Pricing Available
Custom Formulations: azide free, endotoxin testing & endotoxin removal.
Pair your antibody with a Lysate, Peptide, Control, & /OR Secondary Antibody.
Contact our Customer Care Team for more information
Speak to one of our custom antibody specialists to discuss your next custom antibody project.
CATALOG NUMBER: PM-7369-HRP
CATALOG NUMBER: PM-7369-biotin
CATALOG NUMBER: PM-7369
| Cookie | Duration | Description |
|---|---|---|
| cookielawinfo-checbox-analytics | 11 months | This cookie is set by GDPR Cookie Consent plugin. The cookie is used to store the user consent for the cookies in the category "Analytics". |
| cookielawinfo-checbox-functional | 11 months | The cookie is set by GDPR cookie consent to record the user consent for the cookies in the category "Functional". |
| cookielawinfo-checbox-others | 11 months | This cookie is set by GDPR Cookie Consent plugin. The cookie is used to store the user consent for the cookies in the category "Other. |
| cookielawinfo-checkbox-necessary | 11 months | This cookie is set by GDPR Cookie Consent plugin. The cookies is used to store the user consent for the cookies in the category "Necessary". |
| cookielawinfo-checkbox-performance | 11 months | This cookie is set by GDPR Cookie Consent plugin. The cookie is used to store the user consent for the cookies in the category "Performance". |
| viewed_cookie_policy | 11 months | The cookie is set by the GDPR Cookie Consent plugin and is used to store whether or not user has consented to the use of cookies. It does not store any personal data. |